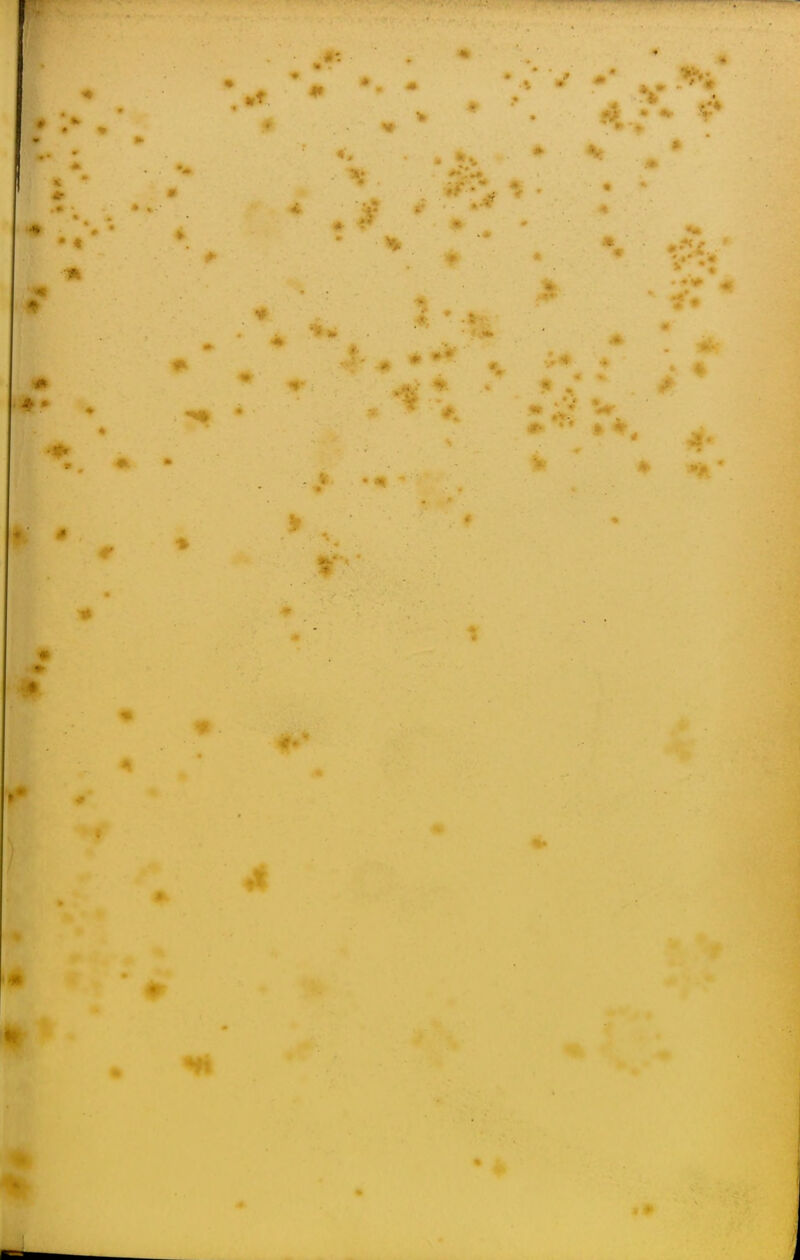
# ' .7

The pantropheon or, history of food, and its preparation, from the earliest ages of the world / A. Soyer.
- Soyer, Alexis, 1809-1858.
- Date:
- 1853
Licence: Public Domain Mark
Credit: The pantropheon or, history of food, and its preparation, from the earliest ages of the world / A. Soyer. Source: Wellcome Collection.
Provider: This material has been provided by The University of Glasgow Library. The original may be consulted at The University of Glasgow Library.
9/593